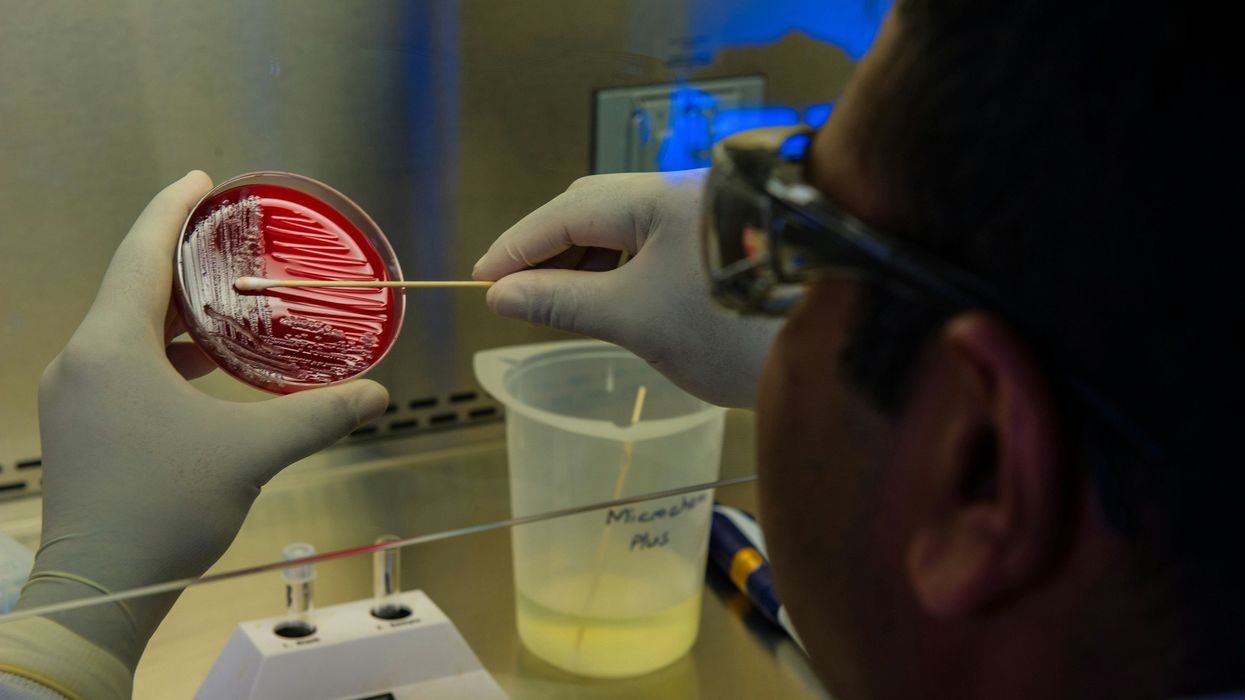
A lab tech swaps at a bacteria culture

A recent review published in Current Opinion in Biotechnology highlights bacteria’s ability to break down PFAAS, a type of toxic PFAS chemical that’s particularly tough to degrade.
In short:
- Both aerobic and anaerobic bacteria are capable of breaking down PFAAS, meaning degradation can take place under a variety of conditions.
- However, existing research on bacterial degradation has only taken place within the lab, leaving a gap in our understanding of PFAAS breakdown in the natural environment.
Key quote:
“Bioremediation of PFAS, if feasible, would potentially be a more cost-effective and environmentally friendly alternative for the mineralization of difficult-to-degrade PFAS.”
Why this matters:
PFAS chemicals - which are found in a wide range of industrial and consumer products - are associated with severe health effects including an increased risk of cancer, liver and kidney damage, and developmental issues in babies and children. Other existing methods of PFAS remediation, like physical removal or chemical treatment, either don’t break down the chemical or result in toxic byproducts. While biodegradation may have the potential to serve as a more sustainable alternative, it’s critical to advocate for regulations that restrict the use of PFAS and address the root of the exposure.
Related EHN coverage:
- Op-ed: After decades of disinformation, the US finally begins regulating PFAS chemicals
- 2024 could be a big year for PFAS bans: Report
- Enlisting microorganisms in the fight against plastic pollution
More resources: To learn more about more approaches researchers are trying to break down PFAS, see Competition to destroy ‘forever chemicals’ heats up by Britt Erickson in Chemical and Engineering News.
Smorada, Chiara et al. for Current Opinion in Biotechnology vol. 88. Aug. 2024